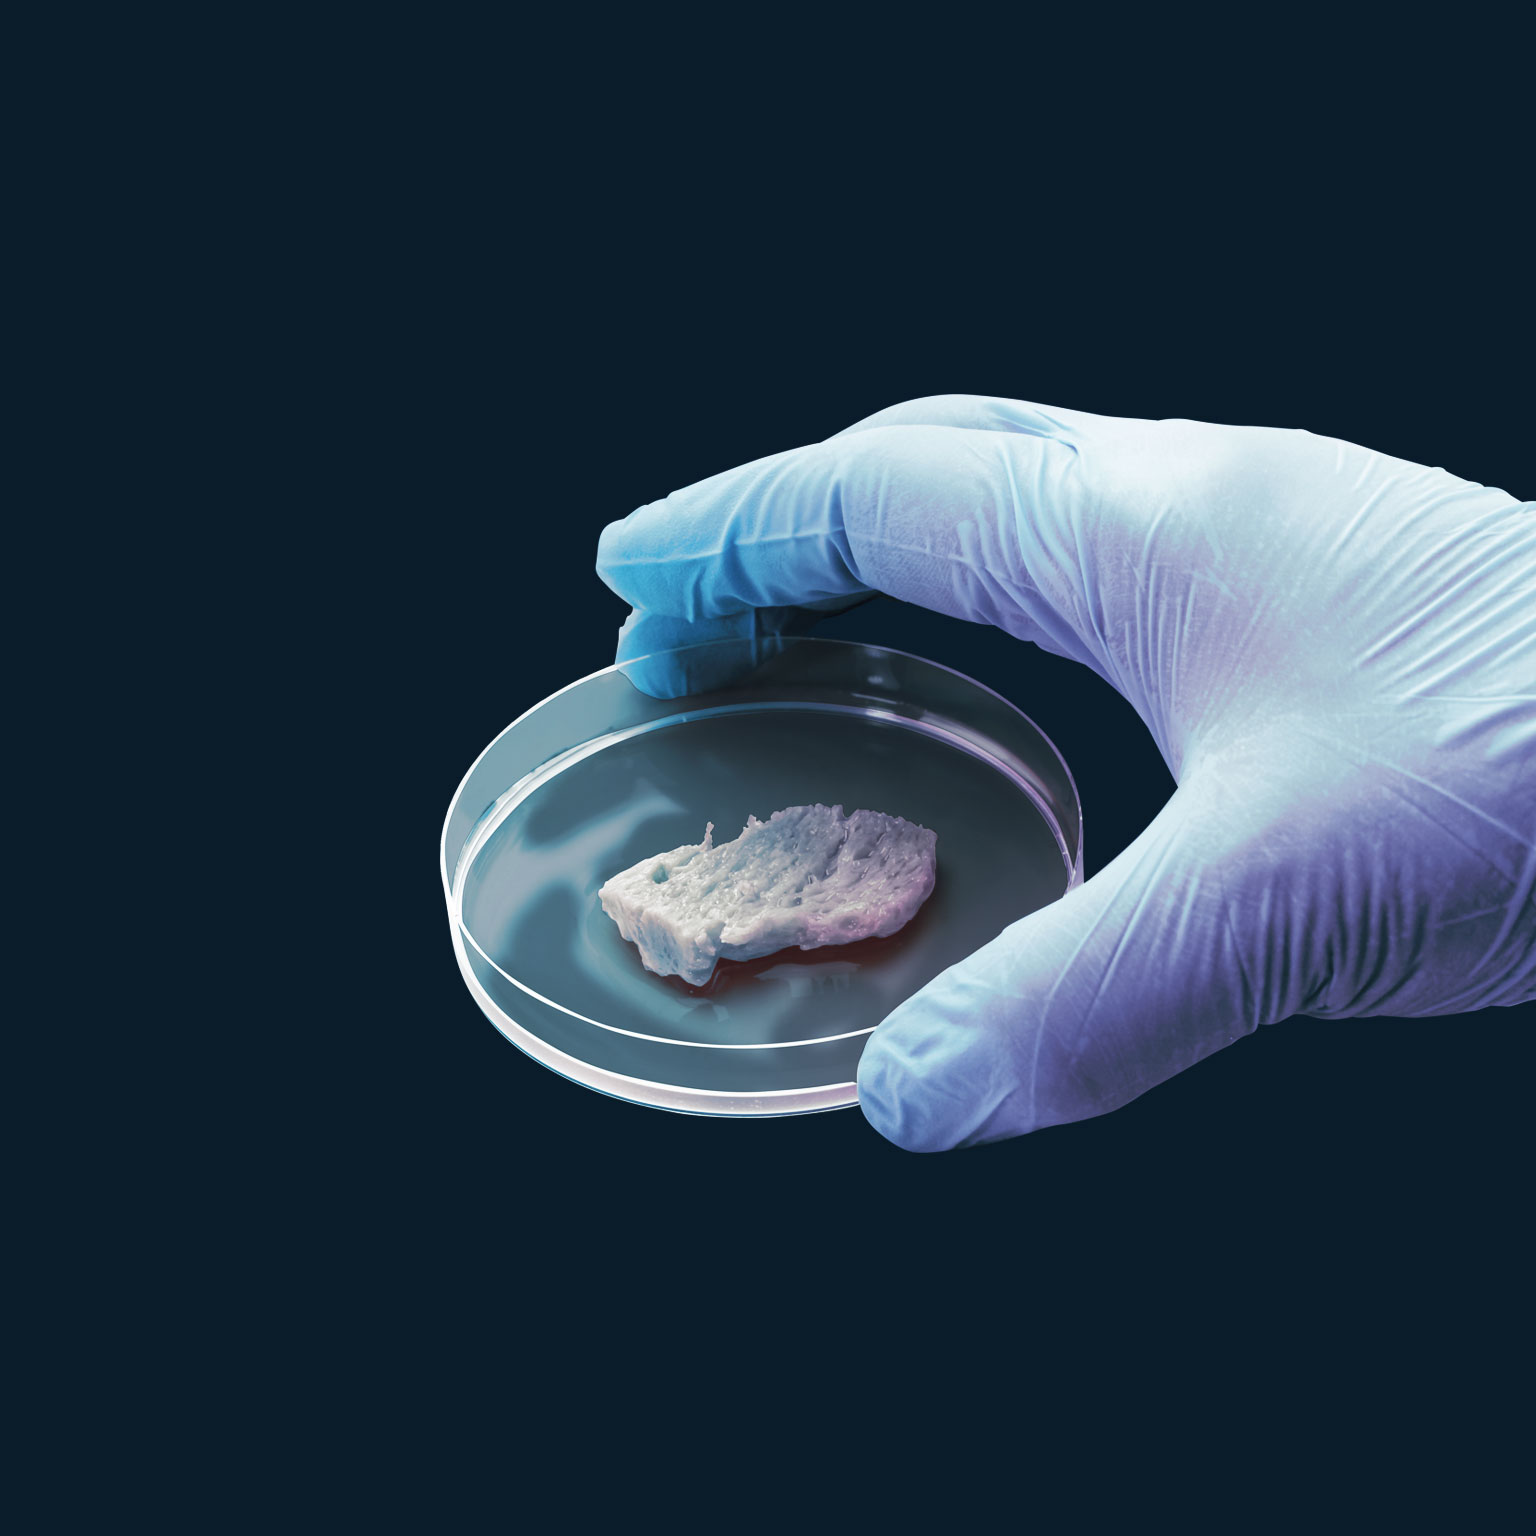

The European red meat processing industry is under pressure. Consumers are increasingly turning away from beef and pork toward poultry and plant-based alternatives,1 prompted by health and environmental concerns as well as the proliferation of meat alternatives. Increasing regulatory requirements, including more attention to food safety, are raising costs that red meat processors cannot pass on to consumers. Meanwhile, wages are increasing in this labor-intensive business. As a result of these and other trends, the processing industry is seeing deeply reduced profit margins and greater consolidation.
These challenges, combined with technological development, have created big incentives for red meat processors to invest in automation. Those that have done so have trimmed labor costs, improved yields, and cut food waste. Automation has also facilitated the production of higher-quality meat and made jobs safer.
In this article, we will look at how processors can maximize the benefits of automation. Leading the way are processors in Germany and Scandinavia, though those in Italy and Spain made considerable investments in 2019. To stay ahead of the pack, processors must continuously adopt and optimize new technology while aligning it with the right market focus and product offering. Consolidation provides the scale to justify automation in this low-margin business. But companies that fail to automate face a significant cost disadvantage, making them less competitive in (currently booming) export markets and eventually threatening their existence.
What’s behind the automation imperative
European consumers ate a total of 60.7 million tons of beef, pork, poultry, sheep, and veal in 2018, but Europeans are eating less of it overall (exhibit).2 Total consumption of beef and pork is expected to stay flat through 2030. Growth in meat production has declined from 1.6 percent a year (2000 to 2015) to 0.6 percent a year (2015 to 2019), and is forecasted to fall in 2020 to 2028 to about 0.2 percent a year. This decline is seen across meats.
Economic growth in the European Union has been sluggish, and real disposable incomes have increased just 0.9 percent a year in the last ten years, making meat less affordable. In addition, population growth in Europe is expected to be between 0.0 and 1.0 percent a year; any growth in eating meat will be from population growth rather than increased consumption per capita. And the challenges go beyond economics and demography—the agriculture industry faces resource issues, including land availability, water scarcity, and other impacts of climate change on farm productivity.
In the medium term, however, the spread of African swine fever throughout China and Southeast Asia has created an opportunity for the European pork processing industry. China’s populations of hogs and sows are estimated to have decreased by about 40 percent year-over-year as of May 2019 because of the disease.3 As a result, Chinese pork imports rose 40 percent in the January to August 2019 period compared with the same interval in 2018, and year-over-year prices of hogs and piglets increased more than 35 percent. The recovery of production capacity could take approximately three years.4 Producers lacking the efficiency, right freezing capacity, or licenses for export to China continue to struggle, while the more efficient at-scale producers are better positioned to capture this opportunity.
At the industry level, labor issues are pressuring companies’ cost bases. Meat processing is heavily dependent on labor, with workers accounting for 10 to 15 percent of company costs. In the face of increasing labor shortages and high worker turnover, wages are rising as well. And regulations to improve food safety, worker conditions, and animal welfare have also led to higher costs.
Would you like to learn more about our Agriculture Practice?
As a result, EBIT5 margins in the European red meat processing industry declined by 33 percent between 2010 and 2017, reaching a record low of about 2 percent in 2019. In response to these trends, the industry has consolidated. Now many companies are building the scale to invest in automation.
Assessing automation’s current status
We categorize red meat (beef and pork) processing into three levels of automation:
- Low automation (level one): limited automation tools implemented. Examples include most cattle plants, where manual labor carries out major processes such as cutting and deboning.
- Semi-automation (level two): some processes automated, with manual labor needed during or in between. Examples include many of France’s abattoirs, where humans use electric equipment.
- Full automation (level three): processes automated as far as possible, and robotics and data tools implemented. Examples include a pork processing plant in Denmark, which uses robot technology for a fully automated option that offers better yield and reduces labor cost.
A shift toward more automated production techniques will shape the beef and pork processing industries over the next five years. The most technologically advanced regions in Europe are expected to reach about 25 percent level 3 automation by 2023, up from 10 percent in 2019.
In beef, the number of processing lines will shift from about 70 percent level one and 30 percent level two in 2019 to about 50 percent level one, 45 percent level two, and 5 percent level three, according to McKinsey forecasts (see sidebar, “How automation may spread in Europe”).
In pork, the number of lines will shift from about 50 percent level one, 40 percent level two, and 10 percent level three to about 20 percent level one, 55 percent level two, and 25 percent level three. Automation will move faster in pork processing because fewer high-value cuts would require more advanced technology to avoid yield losses. Pork is also more homogeneous than beef, making it easier to process by machine than by humans.
However, automation of beef and pork processing is challenging. First, meat is not firm and changes shape when processed, making it harder to apply robotics or other mechanical approaches to plant operations. Second, meat is non-uniform—that is, each carcass is unique, so achieving precise and consistent cuts is difficult. Third, waste is so expensive (especially in beef) that machines must reach accuracy exceeding 99.5 percent. But overcoming the complexity and achieving level-three automation creates a strong competitive position for the most capable processors.
How to think about automation
Beef and pork processors face some complicated considerations and trade-offs as the automation race moves ahead.
Understanding the trade-off between yield and cost
In cases for which automation is applied to reduce manual labor, the impact on yield needs to be understood. Processors must determine, for example, the value of the lost yield on a specific piece of meat as well as other costs they must reduce to counter the yield losses.
Executives should also be aware that automation will shift costs from more flexible manual labor to more fixed maintenance costs. In addition, an automated system is less prone to errors, but those that do occur are significantly more costly than those created by workers.
Taking advantage of improved yields
In cases for which yields improve, processors must better understand the full value of the additional meat that becomes available, including the optimal end uses and markets for certain products (such as pigs with different back lengths). Processors that figure out the best use of technology will be faster to adopt it and are more likely to extract value from it.
Increasing industry collaboration
As production becomes more technology intensive, cooperation between processors and equipment providers will become increasingly important. It will become more and more difficult for processors to service the equipment with in-house personnel. At the same time, as facilities become larger, the cost of errors will rise. These circumstances may encourage closer ties between processors and equipment providers, which may involve offering incentive payments to providers for maximizing equipment uptime or processors testing the latest, most advanced equipment with manufacturers. Processors that foster these kinds of relationships with manufacturers will have automation advantages over their competitors.
What level-three automation means for the industry
The rising level of automation also has broader implications for beef and pork processors. First, the industry will continue to consolidate as scale and production efficiency become increasingly important. The more efficient processors will shift the cost curve and lower prices, pushing less efficient competitors out of business. The degree of technology development and the point at which diminishing returns sets in will be key in determining the speed of consolidation.

How the global supply landscape for meat protein will evolve
Second, we believe consumers will be the main benefactors of continued automation. Red meat is traded on efficient markets in which the lowest prices typically win. In the grocery and food-service sectors, fierce competition and price transparency will transfer value to consumers. Lastly, automation will make the workplace safer but will also require workers to improve their skills to operate new equipment in an abattoir.
The benefits of automation for the red meat processing industry are evident, but realizing them will require CEOs and other senior executives to think carefully about where and how much to invest. High-tech automated equipment is expensive, ranging from €25 million to €50 million for a fully automated pork production line. CEOs may very well need board approval to move ahead with such purchases.
Automation of the red meat processing industry will continue apace, given the market and economic forces at work. Those that put off automation will find themselves at potentially fatal cost disadvantages. However, to take full advantage of the automation, executives must understand its impact on yields and labor-machine cost trade-offs as well as consider committing to working with equipment suppliers to get early access to more advanced technology.